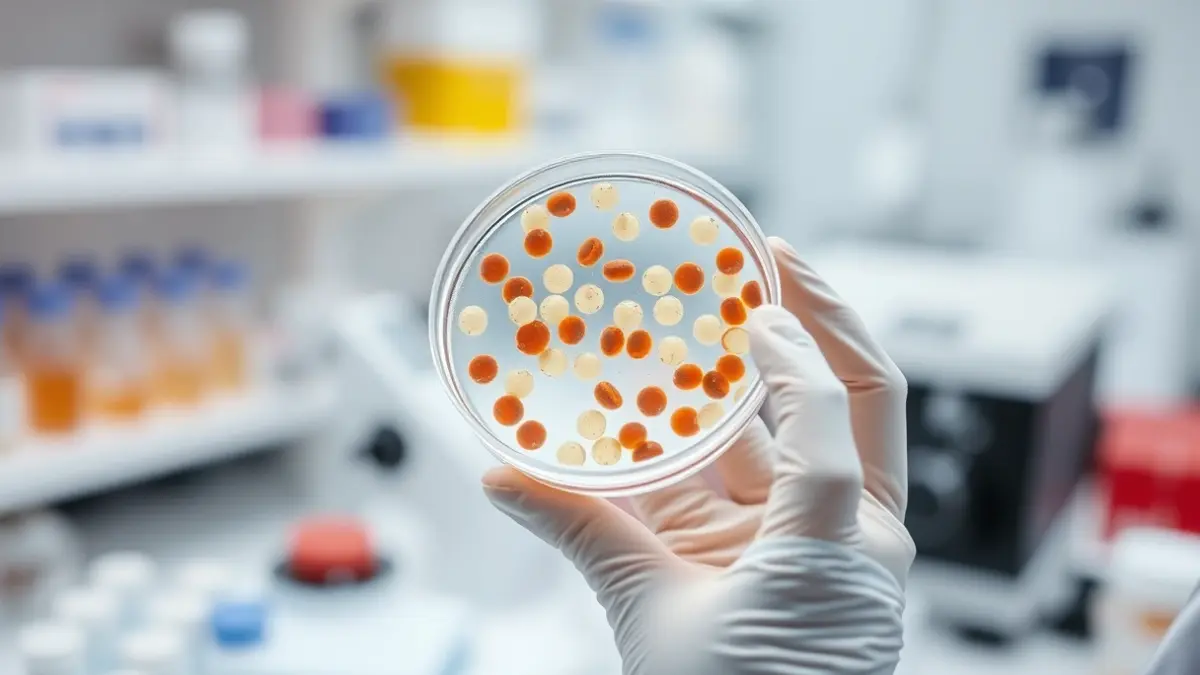
Imatge genèrica d'un investigador mèdic manipulant mostres en un laboratori.

Os de Balaguer, epicentre català de la tradició campanera amb la 38a Trobada
Un centenar de professionals es reuneixen per fer demostracions de tocs manuals i homenatjar el mestre campaner local.
Sense cookies, subscripcions ni publicitat.

La Societat de Pesca Sort-Pirineus organitza activitats per a infants i adults, promovent la pesca sense mort i la conservació del riu Noguera Pallaresa.
Un estudi internacional, amb participació de l'Hospital Vall d'Hebron, valida un medicament que duplica la supervivència i millora la qualitat de vida dels pacients.

L'equip reusenc s'imposa per la mínima a la UE Olot i es jugarà la classificació a la darrera jornada contra el Terrassa FC.

El partit exigeix una rectificació immediata i es reserva el dret a emprendre accions legals davant les acusacions.

L'equip roig-i-negre va vèncer la UE Olot per la mínima, mantenint vives les seves aspiracions de promoció a Primera RFEF.

Uns 30.000 residents de cinc municipis rebran un missatge de prova al seu telèfon per avaluar el sistema ES-Alert.

La Colla Jove de L'Hospitalet va aconseguir descarregar un 3 de 6, mentre que els Castellers de Viladecans i els Carellots de Sant Vicençs dels Horts també van realitzar importants construccions.

La subvenció municipal per a la compra de vehicles elèctrics genera confusió entre els usuaris sobre models, tràmits i preus elegibles.

L'organització juvenil va reunir una cinquantena de participants al Parc del Migdia, preparant la manifestació del Primer de Maig a Barcelona.

Un establiment a la Rambla del Prat, tancat des de fa 13 anys, genera preocupació entre els residents després d'haver estat ocupat per la venda de drogues.

La tretzena edició de la cursa, que connecta Girona i Platja d'Aro, ha registrat un augment del 30% d'inscrits.

L'equip egarenc perd 3-1 contra l'Atlético Baleares i es queda sense opcions d'ascens ni de classificació directa per a la competició copera.

L'equip barceloní s'imposa per la mínima a l'Atlètic Terrassa en una final disputada i revalida el títol dos anys després.

La mobilització, convocada per la Plataforma Aturem la Guerra, ha denunciat el suport al règim israelià i l'augment de la despesa militar.

La derrota per 5-2 davant el Caldes deixa el Reus Deportiu en una situació delicada per accedir a la pròxima Champions.

El club de futbol de Reus llança una equipació commemorativa amb motiu de la celebració de l'Any Gaudí, destacant la vinculació amb l'arquitecte.

El Servei Meteorològic de Catalunya i Protecció Civil activen avisos per pluges fortes i possibles inundacions en una dotzena de comarques del Pirineu i Prepirineu.

Els Mossos d'Esquadra han arrestat deu individus i n'han denunciat nou més per danys que superen els 377.000 euros en trens de FGC, Renfe i Metro.

La Fundació Barcelona Promoció organitza una marató de deu hores de música en directe per celebrar el Dia Internacional del Jazz.

L'equip ebrenc va caure 28-29 contra l'Handbol Molins en la Lliga Catalana Or, amb la victòria visitant decidida en l'últim segon.

L'equip del Baix Ebre va vèncer per 7-1, retallant distàncies amb la permanència a la Primera Catalana.

La Planta Pilot MELiSSA, un laboratori de l'Agència Espacial Europea, investiga la reutilització de residus humans per a la supervivència a l'espai.

El CIEMEN i el PEN Català impulsen un procés internacional per adaptar la DUDL als reptes actuals, trenta anys després de la seva proclamació.

Centenars de veïns van gaudir d'una jornada esportiva i de descoberta de l'entorn amb dos recorreguts diferents.

El Tribunal Superior de Justícia de Catalunya ha desestimat els recursos presentats contra els gravàmens municipals per la recollida de residus.

La demarcació de Girona ha registrat múltiples incidències viàries durant la nit de dissabte i la matinada de diumenge, amb diverses persones ferides.

Un grup d'usuaris de vehicles de mobilitat personal va ser captat en vídeo a la C-1415a, infringint diverses normatives de trànsit.

El calendari laboral de 2026 a Catalunya inclou el Dia del Treballador, la Segona Pasqua i Sant Joan, oferint oportunitats per a llargs caps de setmana.

L'antiga líder municipal de Llívia, amb una trajectòria de catorze anys, no descarta presentar-se de nou a les eleccions locals.

El centre cultural de Torroella de Montgrí fa una crida a la ciutadania per recopilar material per a una exposició sobre la mobilització pel riu Ter.

El consistori de Freginals ha llançat una campanya de sensibilització i control per erradicar els abocaments incontrolats, amb multes que poden superar els 3.000 euros.

L'empresa d'Os de Balaguer llança una gamma de mels gurmet en col·laboració i la primera mel amb vitamina B12 del mercat.

Aquestes empreses, que actuen com a pont entre el sector públic i privat, creixen a Madrid i Barcelona, aprofitant la fragmentació política i la complexitat decisòria.

El consistori de Vila-rodona ha donat llum verda al seu pressupost anual, que inclou inversions significatives en el nucli antic i un nou museu interactiu.

El calendari laboral de Mataró per al 2026 ofereix oportunitats per a llargs caps de setmana abans de les vacances d'estiu.

La iniciativa, que respon a una petició veïnal, busca fomentar el lleure familiar i responsable en una zona ombrívola i de pas.

L'Audiència Provincial de Tarragona ha condemnat un home a pagar 360 euros per sostreure 15 llaunes de tonyina d'un establiment a Reus.

Els visitants de la comarca van gastar de mitjana gairebé 850 euros per persona, impulsats per l'increment en allotjament i restauració.

La ciutat es prepara per a la I Trobada Infantil de Gegantons i estrena un espai dedicat a la gimnàstica esportiva.

L'augment de pisos destinats a estudiants estrangers temporals provoca queixes per soroll i incivisme, mentre el Sindicat de Llogaters denuncia preus abusius.

La professional, amb arrels colombianes i catalanes, subratlla que l'ensenyament és una via constant d'aprenentatge i creixement personal.

Els Bombers han hagut d'intervenir per un foc en una sala de comptadors a l'aparcament de l'edifici, sense ferits.

El projecte, amb una inversió de més de 723.000 euros, modernitzarà l'equipament esportiu amb noves grades i millores estructurals.

Un dispositiu policial combinat, amb drons i agents de paisà, busca frenar els danys al patrimoni ferroviari, que superen els 377.000 euros.

La Federació Catalana de Natació ha distingit tres esportistes del club per les seves victòries amb la selecció catalana en campionats europeus i mundials.

La interrupció elèctrica que va afectar la península Ibèrica fa un any va ser la més greu a Europa en dues dècades, amb expedients sancionadors en curs.

La consulta sobre la permanència a l'Aliança Atlàntica va generar un intens debat a Sabadell, on el 'No' es va imposar amb una participació del 68%.

La Guia botànica de Tarragona, que ha esgotat la seva primera edició, aprofundeix en els beneficis de plantes com la garrofa i la farigola.

La reorientació de les rutes marítimes per evitar el Mar Roig allarga els terminis de lliurament i encareix els productes per als consumidors.

El conjunt roig-i-negre afronta un duel clau a l'Estadi per accedir a la promoció d'ascens a Primera RFEF, amb el retorn de Ramon Folch.

La Comissió Europea proposa una taxa de tramitació de 2 euros per enviament i eliminar l'exempció aranzelària per a paquets petits.

El consistori de Deltebre ha donat llum verda per unanimitat al III Pla Municipal de Polítiques de Dones, que guiarà les accions d'igualtat fins al 2031.

El reconegut restaurant amb dues estrelles Michelin a la Garrotxa integra la visió de les filles dels fundadors, reforçant la seva aposta per la natura i la proximitat.

Les obres, amb una inversió de 120.000 euros, busquen donar més visibilitat al nucli urbà i millorar la circulació.

La parròquia de Santa Susanna del Mercadal a Girona atrau diàriament més de seixanta fidels a la missa de les nou del matí.

Una conferència clandestina a Dosrius l'any 1946 va idear un atemptat contra el dictador a Barcelona, revelant la resistència catalana de postguerra.

El municipi de l'Alt Camp celebrarà la seva festa petita amb activitats per a totes les edats, incloent la tradicional Festa de la Gent Gran.

Un dispositiu conjunt de diversos cossos de seguretat es va saldar amb la confiscació de marihuana i una persona arrestada per infracció de la llei d'estrangeria.

Centenars de persones van assistir a l'esdeveniment als Jardinets de l'antiga Caixa Sabadell per conèixer la tasca del tercer sector.

La trobada, organitzada per La Taula Sabadellenca per la Llengua, ha reunit diverses entitats per intercanviar experiències i proposar accions concretes.

La decisió arriba després d'un any i mig de gestió, a causa de la manca de garanties sobre les obres d'insonorització i les restriccions d'activitat.

La IV Nit de l'Humor al Teatre Victòria va celebrar el retorn del trio còmic en suport de l'ONG Dream Nepal, que rescata infants de la presó.

El barri de la Zona Franca de Barcelona acull una iniciativa per redescobrir els seus espais i equipaments arquitectònics.

L'esdeveniment, que s'allargarà fins al 7 de juny, combina cuina, promoció territorial i activitats per a tots els públics.

La decisió de l'empresa gestora, Barcelona Events Musicals, arriba per la incertesa en les obres d'insonorització obligatòries.

El pedagog i activista Josep Vila assumeix la presidència de l'Assemblea Nacional Catalana, amb Lluís Llach com a vicepresident.

L'empresa gestora renuncia a la concessió municipal després de problemes amb queixes veïnals i obres d'insonorització.

La pròrroga continuada del servei de recollida de residus a Lleida, adjudicat fa dues dècades, ha provocat un augment de la pressió fiscal i un empitjorament de la qualitat.

L'assemblea de l'entitat independentista ha escollit la nova direcció en una reunió celebrada a Igualada, amb Lluís Llach com a vicepresident.

Els treballadors de la xarxa de biblioteques de la capital catalana inicien una vaga de dissabtes per reclamar millors condicions i plantilles adequades.

La militància local ha designat l'actual regidora, amb experiència tant en el govern com en l'oposició municipal.

La formació política reivindica el paper dels ajuntaments en la gestió de l'habitatge i proposa una fiscalitat adaptada als grans tenidors.

La Creu Roja ha avaluat els aspirants a socorristes per a les platges de Tarragona, l'Ametlla de Mar i Deltebre amb un duatló i simulacres de rescat.

L'esdeveniment reuneix mig centenar de marques i 7.000 m² d'exposició a firaReus, amb activitats fins al 26 d'abril.

L'equip de Mats Zilken necessita una victòria contra Las Rozas per dependre de si mateix en la lluita per evitar el descens.

Centenars de persones passen cada any pel Centre d'Internament d'Estrangers de la Zona Franca, on la majoria no han comès delictes.

El certamen, que se celebra al Pavelló d'Inpacsa, ofereix una àmplia mostra de comerços, serveis i entitats locals durant tot el cap de setmana.

La nova 'Masía Gallery' de la marca, inspirada en l'art, ha atret desenes de persones que van esperar hores per ser les primeres a entrar.

L'entitat celebra el seu trentè aniversari amb el reconeixement de ser la pregonera de les festes de la ciutat.

El club de futbol ha presentat un recurs d'alçada davant l'Oficina Espanyola de Patentes i Marques, al·legant risc de confusió.

Estudiants de l'Escola Vedruna Vall van exposar la problemàtica de l'accés a l'habitatge per als joves durant la sessió plenària.

El pedagog i activista Josep Vila assumeix la presidència de l'Assemblea Nacional Catalana, amb Lluís Llach com a vicepresident.

L'Ajuntament de Barcelona ha creat l'Àgora de Serveis Socials, una assemblea deliberativa amb 100 usuaris per recollir propostes de millora.

El consistori barceloní ha decidit preservar el rètol icònic de la marca de begudes, un símbol del disseny dels anys 30, que es troba a la façana de l'antiga fàbrica del Poblenou.

La quarta trobada de cap de setmana del gabinet se centra en els pressupostos, Rodalies i les crisis d'educació i sanitat.

La mesura, publicada al DOGC, eleva el límit d'ingressos i el topall del lloguer, beneficiant milers de famílies.

La celebració de Sant Jordi a la comarca de l'Alt Camp esdevé un punt de trobada entre generacions, on la memòria dels avis enriqueix la festa.

L'entitat independentista ha nomenat Josep Vila per liderar el Secretariat Nacional, amb l'objectiu de fer l'organització més àgil i adaptada al context actual.

L'artista català, conegut per la seva participació a Eufòria i l'èxit de Rikiti, revela detalls personals i professionals en una entrevista.

La vila tarragonina acull propostes itinerants, titelles i recreacions històriques per a tots els públics en els darrers dies de la celebració.

La fundació va atendre gairebé 2.500 persones a la demarcació gironina l'any passat, amb un pressupost que va créixer un 14,8%.

Un estudi revela la dramàtica situació dels pacients psiquiàtrics a Reus, amb centenars de morts per fam i manca de recursos durant el conflicte bèl·lic.

La participant ha obtingut el 63% dels vots del públic, superant els altres finalistes del concurs musical de 3Cat.

Desenes de persones han passat la nit al carrer per aconseguir cita prèvia per a tràmits d'estrangeria a l'oficina de la capital catalana.

Desenes de persones han passat la nit a l'exterior de l'Oficina d'Atenció Ciutadana Monumental per aconseguir cita prèvia.

L'organisme regulador ha obert 35 expedients addicionals, sumant-se als 20 ja existents, amb Iberdrola i Endesa com les empreses més afectades.

El foc, que va cremar dues habitacions d'un pis a la ronda de Ferran Puig, va ser extingit ràpidament pels Bombers.

La iniciativa busca integrar els centres de regulació i gestió d'operacions per millorar la coordinació i la informació als usuaris, tot i que la data i ubicació final encara no estan definides.

La banda de rock català ha començat la seva gira d'aniversari al festival Strenes, repassant els seus grans èxits davant un públic entregat.

Una botiga efímera obrirà les seves portes a Ciutat Vella amb samarretes i souvenirs autèntics de futbol vintage, coincidint amb el partit entre el Barça i el Madrid.

La jornada, pensada per a tota la família, oferirà propostes de joc, exploració i creativitat amb la música com a eix central.

La iniciativa agrupa 23 organitzacions del Tercer Sector Social que donen suport a prop de 16.000 persones a la ciutat.

Una cinquantena de professionals es reuneixen al Monestir d'Avinganya per impulsar la col·laboració entre centres educatius i entitats culturals.

El procés extraordinari per obtenir documentació ha registrat un gran volum de peticions, amb la via telemàtica com a principal canal.

La pianista ha presentat el seu darrer treball al Teatre Bartrina, oferint un espectacle íntim i estètic que ha captivat el públic.

El mitjà local anticipa la commemoració del seu mig segle d'història amb un projecte participatiu que connectarà amb la ciutat.

La Generalitat, a través dels Agents Rurals, ha començat a col·locar barreres provisionals per limitar la mobilitat dels senglars al Vallès Occidental.

La consellera d'Interior destaca la reducció de delictes patrimonials i l'augment de la presència policial com a èxits de l'estratègia.

La Coordinadora d'ONGs Solidàries de les comarques gironines i l'Alt Maresme celebra la primera edició del guardó a Figueres.

Una directora de Reus, establerta a Londres, presenta la seva primera pel·lícula al prestigiós Festival de Canes, explorant la immortalitat i el sentit de l'existència.

Un expert en medicina fetal destaca els avenços en ecografia i tests no invasius, i la seva visió de futur per a la detecció de trastorns genètics.

La Policia Local i els Mossos d'Esquadra van actuar ràpidament després que les càmeres detectessin un robatori en una furgoneta.

Un establiment de la Devesa s'ha consolidat com a referent gràcies a la seva aposta per la vedella Angus i el pernil ibèric.

L'esdeveniment, centrat en empresa, comunicació i influència, comptarà amb ponents destacats i un sistema de traducció amb IA.

La Paeria ha lliurat la medalla al mèrit esportiu a Dani Badia, destacant la seva tasca en la preservació del patrimoni local.

La iniciativa de la Generalitat de Catalunya ofereix estades a preus reduïts en albergs, incloent opcions per a mascotes i descomptes per a famílies nombroses.

Les tasques de reparació en quatre túnels de la línia R-13 obligaran a un transport alternatiu per carretera durant dos mesos.

Els municipis d'Ascó i Vandellòs, on es concentren els reactors, defensen la continuïtat de les plantes per la seva importància energètica i econòmica.

La integració dels centres de control d'Adif i Renfe busca optimitzar la gestió i la informació als viatgers, superant la històrica desconnexió.

Els apicultors de la regió de Lleida denuncien una "extraordinària pressió" sobre les colmenes i la insuficiència de les mesures de la Generalitat.

El club de tennis taula de l'Alt Empordà ha decidit no arriscar la seva viabilitat financera davant la baixa d'un jugador clau per ansietat.

La programació del diumenge 26 d'abril inclou des de trobades de puntaires fins a concerts i teatre musical per a tots els públics.

L'operadora ferroviària ha incorporat personal especialitzat per millorar la gestió d'incidències i la coordinació amb Adif.

El Consell Comarcal aprova una moció per revisar totes les instal·lacions i actuar d'urgència a la de Vall-llobrega, afectada per un temporal.

La CNMC ha iniciat 34 nous expedients sancionadors contra diverses companyies, incloent Iberdrola i Endesa, per possibles irregularitats en instal·lacions elèctriques.

La mesura, que s'iniciarà la setmana vinent, busca millorar la convivència escolar, tot i el rebuig de sindicats i associacions de famílies.

La iniciativa del Govern per introduir agents de paisà en instituts de l'Urgell i la Val d'Aran genera una forta oposició de sindicats i entitats educatives.

La decisió de l'Audiència de Lleida confirma la responsabilitat parcial de la instal·lació per la manca de barreres de seguretat.

L'exemplar, que va ser trobat com a cria, ha estat tractat durant un any per una intoxicació amb rodenticides anticoagulants.

Les obres de la promoció d'habitatge de protecció oficial a Reus ja estan al 90% d'execució i es preveu que finalitzin al juny.

La trobada, organitzada per la Cambra de Comerç i Àgora Diplomàtica, busca enfortir els llaços econòmics i explorar oportunitats d'inversió.

La Comissió Nacional dels Mercats i la Competència ha iniciat quinze nous procediments, sumant un total de 35, arran de la investigació sobre la interrupció del subministrament elèctric.

Els alumnes de la llar d'infants Els Merlets van ser els protagonistes d'una jornada festiva a Montblanc.

Els derbis egarencs entre l'Atlètic Terrassa i el Club Egara han marcat l'inici de les competicions amb victòries ajustades.

El Consell Plenari de l'Ajuntament ha aprovat la incorporació de cinc arbres al registre municipal que protegeix el patrimoni verd de la ciutat.

L'organisme regulador ha obert un expedient qualificat de 'molt greu' contra Red Eléctrica i investiga altres grans operadors del sector.

La localitat del Vallès Occidental acollirà diverses activitats els dies 25 i 26 d'abril, incloent un taller d'autoreparació, un laboratori creatiu i una trobada de guitarres.

El sabadellenc, amb una dècada d'experiència, destaca la mentalitat professional de l'equip i la il·lusió per la Champions.

A només mitja hora d'Igualada, aquesta petita localitat de l'Anoia ofereix un paisatge espectacular i un llegat històric notable.

La prova pilot, amb una inversió de més de 65.000 euros, busca optimitzar l'accessibilitat i reduir l'impacte visual del mobiliari urbà.

La iniciativa de la Generalitat busca reforçar la seguretat i el benestar de l'alumnat amb la presència de Mossos d'Esquadra en un centre educatiu.

La companyia elèctrica ha completat la instal·lació d'una nova anella elèctrica a Coll de Nargó per millorar la fiabilitat del servei.

La publicació, fruit d'una aliança editorial, ha esdevingut un dels títols més destacats de la diada de Sant Jordi a la capital del Segrià.

La iniciativa busca transformar les estructures inacabades en habitatges eficients amb tècniques de bioconstrucció i materials sostenibles.

Diversos municipis de la regió ofereixen una àmplia gamma d'activitats, des de festivals de cinema i fires gastronòmiques fins a festes majors i trobades tradicionals.

Les dades revelen un increment del 40% en les condemnes i una reducció del 40% en els delictes els primers mesos del 2026.

El CaixaResearch Institute, finançat amb 100 milions d'euros, acollirà mig miler de científics per investigar malalties complexes.

El calendari laboral de 2026 a L'Hospitalet de Llobregat inclou el Dia del Treballador, la Segona Pasqua i la possibilitat d'un llarg pont per Sant Joan.

La capital d'Osona, amb el seu ric patrimoni medieval, ha servit de teló de fons per a reconegudes produccions de cinema i televisió.

L'ampliació pressupostària reforçarà línies de subvenció per a ajuntaments i entitats locals, incloent fons per a danys meteorològics i projectes culturals.

L'entitat bancària ha dipositat la quantitat per indemnitzar la cooperativa i els impositors afectats, buscant la retirada de càrrecs contra dos exempleats i l'antiga Bankia.

Un error humà en la barreja de productes de neteja va provocar un núvol tòxic que va obligar a evacuar la instal·lació.

Usuaris amb mobilitat reduïda denuncien les dificultats d'accés a l'establiment, que l'hospital preveu reformar aquest estiu.

Dos agents de l'ARRO es van retrobar amb la família d'una nena de dos anys a la comissaria de Lleida, després d'haver-la rescatat d'un ofegament.

El CF Lloret i la Juventus Lloret afronten partits clau en la Primera Catalana, mentre que el Bàsquet Lloret busca trencar la seva mala ratxa.

L'actuació, amb un cost de 90.149 euros, ha permès recuperar un espai patrimonial de gran valor històric i paisatgístic.

La formació municipalista ha anunciat la continuïtat del seu actual regidor al capdavant de la candidatura per als propers comicis locals.

El projecte, amb una inversió de 145 milions d'euros, preveu generar 1.400 llocs de treball i obrir a finals de 2027 a la zona de Torre Salses.

La iniciativa conjunta de Lleida Televisió i el Grup SEGRE va captar més de 350 fotografies durant la diada, superant el mig miler de participants.

Una trentena d'acadèmics van gaudir d'un menú especial i un maridatge de vins i caves locals en una visita a un reconegut establiment de l'Alt Camp.

La gestió municipal de Balaguer ha estat qüestionada per la pèrdua de subvencions i el pagament d'interessos de demora per projectes no executats a temps.

La celebració va omplir l'eix literari de la ciutat, amb una nova distribució de parades que va millorar l'experiència dels assistents.

El document, fruit de la col·laboració amb la Fundació URV, estableix 14 eixos estratègics per a la igualtat de gènere.

El mercat hipotecari català registra un creixement interanual del 16,5% i encadena 20 mesos d'increments, amb un import mitjà rècord.

La decisió judicial afecta a part dels onze arrestats en una operació dels Mossos d'Esquadra a Lleida i Seròs.

La sessió ordinària d'abril de l'Ajuntament de Barcelona ha estat marcada per la resolució urbanística de dos equipaments clau i el debat sobre la regularització de migrants.

Les administracions ofereixen diverses línies de suport per facilitar l'accés a l'habitatge, amb terminis i requisits específics per a diferents col·lectius.

La comarca de l'Alt Camp presenta diverses propostes per gaudir del cap de setmana, incloent teatre, exposicions, concerts, trobades de motos i festes locals.

La comarca registra un saldo migratori intern positiu de 331 persones, amb Valls com a principal motor d'atracció i altres municipis guanyant pes.

Una selecció de dotze pics emblemàtics a l'Alt Empordà i Girona que ofereixen rutes per a tots els amants de la muntanya.

L'home, amb un historial de 16 detencions, revenia el material sostret, valorat en 2.000 euros, a través de plataformes de segona mà.

La reconeguda cadena de restauració s'instal·la al parc temàtic de la Costa Daurada amb un local accessible per a tothom.

La combinació d'estrenes i cinema d'autor, juntament amb la dedicació d'un centenar de voluntaris, ha estat clau per a l'èxit de l'equipament cultural.

Diverses unitats dels Mossos d'Esquadra han participat en un operatiu matinal al carrer Riu Cardener, fruit d'una investigació en curs.

L'esdeveniment, dedicat a editorials i arts gràfiques, oferirà tallers, presentacions de llibres i un concert d'arpa durant tot el dia.

La gala de premis, celebrada a Corbera d'Ebre, ha marcat l'inici d'un cicle d'activitats enològiques i culturals que s'estendran fins al 16 de maig.

La comarca del Maresme ha vist un increment de gairebé 2.750 residents estrangers, mentre la CUP de Malgrat de Mar exigeix més participació en la gestió del Pla de Grau.

La comarca del Maresme ha registrat un augment significatiu de residents estrangers, tot i que la seva proporció continua sent inferior a la mitjana de Catalunya.

El nou equipament, finançat parcialment amb fons Next Generation, amplia l'oferta educativa amb 41 places per a infants de 0 a 3 anys.

Un expert de la Universitat de Lleida desmunta el mite de la "maledicció" de la tercera generació en la gestió empresarial.

El foc, originat per una olla oblidada al foc, va generar una gran quantitat de fum que va afectar tot l'edifici de tres plantes.

L'informe anual de la defensora ciutadana de Palamós destaca la negativa de propietaris a empadronar llogaters i la manca de recursos en serveis socials.

La Generalitat inverteix en infraestructures, regeneració urbana i cohesió social per millorar la qualitat de vida a l'àrea de Barcelona.

La ciutat de Figueres acollirà més de 150 activitats, incloent concerts, cultura popular i el retorn del castell de focs al Castell de Sant Ferran.

La 53a edició de la celebració andalusa al Parc del Fòrum recupera l'entrada lliure després d'un intent de pagament l'any anterior.

El programa municipal busca transformar murs cecs en façanes eficients i estèticament integrades, amb incentius per a projectes amb obertures.

El negoci, que va començar com una cafeteria, ha evolucionat fins a esdevenir un referent en la producció per a restauració i càterings.

La manca d'il·luminació, el manteniment deficient i l'incivisme transformen l'espai en un lloc poc segur a la nit, segons l'informe veïnal.

L'edició d'enguany del Festival Grec, amb epicentre a Montjuïc, oferirà un centenar d'espectacles que combinen clàssics i innovació.

El certamen de cinema rural a Juneda ha donat el tret de sortida amb una projecció especial i la presència d'un familiar de l'actor homenatjat.

Les obres dels dos ascensors panoràmics i passarel·les a Tortosa entren en la fase més visible, millorant l'accessibilitat a l'Hospital Verge de la Cinta.

Una nova eina, fruit de la col·laboració entre la URV i el programa INSERLAB, promet fer accessibles documents tècnics i legals a tothom.

La comarca ofereix una àmplia agenda amb concerts, teatre, fires, rutes guiades i festes majors per a tots els públics.

L'esdeveniment musical al Parc de les Aigües de Figueres oferirà onze actuacions i una desena de barraques durant les Fires de la Santa Creu.

La mobilització, que va aplegar unes 300 persones, s'emmarca en una convocatòria nacional per denunciar l'emergència lingüística.

La proposta teatralitzada, que ha rebut diversos premis, busca destacar la trajectòria musical de l'artista més enllà del seu èxit més conegut.

L'operació dels Mossos d'Esquadra a Santa Bàrbara va revelar una defraudació elèctrica de 40.000 euros en una casa amb 1.132 plantes de cànnabis.

La diada ha destacat per l'alta participació i l'èxit de les obres d'autors de la comarca, amb temàtiques històriques i novetats juvenils.

Una patrulla de la unitat penitenciària va assistir un part d'urgència al voral de la carretera, prop de Castellbell i el Vilar, el 23 d'abril.

L'Ajuntament de Terrassa, amb el suport d'ERC, aprovarà un cens per analitzar la distribució comercial i podria suspendre temporalment llicències en zones saturades.

La iniciativa, amb el suport de diverses entitats, busca reconèixer els millors projectes de cicles formatius i programes d'inserció de la província de Barcelona.

El nombre de residents de les comarques de Lleida fora d'Espanya ha crescut un 5,6% el 2026, destacant l'increment del 17,4% a la Noguera.

L'Ajuntament de Lleida planteja una ordenança per prohibir el vel integral en espais públics, provocant reaccions diverses entre partits i governs.

La jornada primaveral ha inclòs contacontes, sardanes, lectura de poemes i l'encesa del Drac, amb gran implicació dels centres educatius.

El Consell Comarcal de la Terra Alta ha atès prop de 200 persones per a la regularització, moltes d'elles joves i procedents de l'economia submergida.

Els Mossos d'Esquadra van arrestar tres adults i un menor d'edat després de causar danys a retrovisors de cotxes al carrer del Nord.

El sector professional de floristes espera superar els 2,5 milions de roses venudes a Catalunya, amb un interès creixent per les roses d'autor.

Una prova pilot a diverses zones de Catalunya, incloent Tàrrega, busca reforçar la prevenció i el benestar de l'alumnat amb agents integrats.

La iniciativa, fruit de la col·laboració entre una entitat ambiental i una marca automobilística, transforma residus marins en bancs i papereres per a la plaça Catalunya.

La Federació de Fires de Catalunya ha nomenat un nou vicepresident segon, un tècnic amb una llarga trajectòria a Fira de Mollerussa.

La celebració del 23 d'abril a Sabadell va destacar per l'alta participació ciutadana i la convivència entre llibreries locals i grans cadenes.

Els nous responsables del local a Gràcia busquen transformar la percepció del veïnat, apostant per un ambient més tranquil i activitats culturals.

La darrera edició del certamen, organitzat per la Diputació de Tarragona i la URV, ha reunit 325 alumnes de 21 centres educatius.

El partit, que es jugarà a la Verneda, serà clau per a les aspiracions de permanència dels locals i l'ascens dels visitants.

La capital de la Noguera es vesteix de festa amb una vintena de parades i una àmplia agenda cultural per a totes les edats.

Malgrat el cel cobert i algunes gotes, la capital ebrenca ha viscut una jornada de Sant Jordi amb gran participació i bones vendes de llibres i roses.

Una autora resident a el Perelló ha creat un innovador llibre per a nens de 3 a 6 anys que combina activitats d'acolorir amb l'aprenentatge de vocabulari bàsic en anglès, incloent codis QR per a la p…

El centre de reutilització de la Mancomunitat Penedès-Garraf ha donat una segona vida a milers d'articles, evitant que acabin a l'abocador.

La popular crema d'avellanes i cacau llança 17 dissenys de pots inspirats en paisatges i edificis icònics d'Espanya.

La formació anticapitalista denuncia un tracte discriminatori per part de l'Ajuntament de Barcelona en la gestió de l'espai públic.

El consistori barceloní sol·licita una modificació de la regulació de la RFEF sobre gespa natural, sense abordar el canvi immediat al Narcís Sala i al Nou Sardenya.

La Plaça del municipi es va omplir de veïns i visitants per gaudir de la diada amb activitats per a totes les edats i un ambient festiu.

Un total de 165 iniciatives rebran suport financer per impulsar el sector pesquer i el patrimoni marítim, amb una inversió global de 6 milions d'euros.

Un projecte immersiu permet als estudiants de l'Institut Mercè Rodoreda viatjar al passat i conèixer el patrimoni català de manera innovadora.

La ciutat acollirà un ampli programa d'activitats culturals, musicals i familiars del 23 al 26 d'abril, incloent la diada de Sant Jordi.

La diada de Sant Jordi a Barcelona comença amb tranquil·litat, però el pol·len dels plataners es converteix en el protagonista inesperat de la jornada.

La celebració del Dia del Llibre a la capital catalana reubica les seves parades principals a Ciutat Vella, mantenint l'esperit festiu malgrat les obres.

Més de 200 persones i sis entitats locals han col·laborat en la creació d'aquesta instal·lació artística amb 20.000 metres de llana.

La ciutat de l'Urgell va viure una jornada festiva amb un mercat de llibres i roses, lectures col·lectives i novetats editorials locals.

El pla pilot, que inclou agents de paisà no armats, busca reforçar la convivència escolar, tot i l'oposició de docents i famílies.

La investigació es va iniciar després que un home acudís a un centre sanitari amb una ferida de bala accidental a la mà.

La Plaça Major de Montblanc es converteix en el cor de la celebració amb centenars de persones gaudint de llibres i roses.

El restaurant El Surtidor de Vilanova i la Geltrú ha guanyat el premi a la millor hamburguesa local al concurs The Champions Burger de Barcelona amb la seva creació Imperial Wagyu.

El calendari laboral de la ciutat inclou diversos dies no laborables, amb la possibilitat de gaudir de llargs caps de setmana i un superpont al juny.

El projecte, amb una inversió de 151.900 euros, busca garantir la sostenibilitat i eficiència de la xarxa hídrica de la ciutat.

Les famílies interessades en el curs 2026-2027 podran tramitar les sol·licituds telemàticament a partir del 8 de maig.

La formació política critica que se'ls negui una parada a la Rambla de Catalunya mentre s'autoritza una a la policia espanyola.

La diada de Sant Jordi a Girona ha destacat per l'homenatge a la poeta centenària Isabel Oliva i Prat i l'estrena d'un acte propi de l'Ajuntament dedicat a Rosa Font Massot.

La capital de la Garrotxa ha fusionat per primera vegada la tradicional diada de Sant Jordi amb el festival de dansa Sismògraf, oferint una programació especial.

La investigació es va iniciar a l'abril arran d'una alerta per una fuita d'aigua en un domicili de la localitat del Montsià.

La investigació, iniciada per una fuita d'aigua, va revelar una plantació amb més de 1.100 plantes i un frau de 40.000 euros.

La iniciativa cultural, que reivindica la unitat de la llengua catalana, fa parada a la ciutat abans de continuar el seu recorregut cap al País Valencià.

La ciutat de Reus ha donat el tret de sortida a les celebracions de Sant Jordi amb una revetlla literària que ha presentat 205 novetats d'autors locals.

La vuitena edició de l'esdeveniment, que inclou la Final Nacional de Catalunya, se celebrarà al Pavelló Olímpic Municipal.

Un projecte pilot del Departament d'Educació desplegarà agents dels Mossos d'Esquadra en diversos centres per prevenir conflictes i donar suport.

La formació política ha anunciat la seva cap de llista per a les pròximes eleccions municipals, destacant la seva experiència i compromís amb la ciutat.

El cap de l'executiu català subratlla el compromís amb la regularització de migrants i la promoció del català.

La ciutat de Figueres va ser l'escenari del lliurament dels reconeixements a l'excel·lència acadèmica en humanitats, ciències socials i medi ambient.

L'adquisició d'immobles nous impulsa el mercat, amb un augment del 17,5% interanual, mentre que els usats creixen més moderadament.

El consistori ha incrementat significativament la partida pressupostària per a asfaltatge i arranjament d'espais públics, prioritzant les zones més deteriorades i amb més trànsit.

La modificació inicial de la normativa busca terrasses més accessibles i clares, amb requisits de lavabos i ordenació d'elements.

La patronal adverteix d'una davallada significativa en el turisme escolar a la comarca i l'Alt Pirineu a causa de les protestes docents.

El restaurant, ubicat al Born de Barcelona, aposta per una cuina oriental, principalment japonesa, que dialoga amb la gastronomia local.

El municipi de la Noguera acollirà el primer cap de setmana de maig la fira dedicada a la cuina dels caragols, amb gastronomia, mercat i activitats.

La ciutat de l'Alt Empordà acollirà una àmplia programació cultural i lúdica del 24 d'abril al 3 de maig, amb propostes per a tots els públics.

L'entitat ha celebrat un sopar benèfic per al projecte OIKIA de Creu Roja i prepara una taula rodona sobre qualitat de vida.

La ciutat acollirà la Flama del Correllengua i diverses manifestacions per defensar el català i exigir mesures a les administracions.

Un robatori de coure va provocar un incendi de vegetació i la suspensió del servei durant dues hores a la zona.

L'Ajuntament de Lleida obre una oficina per atendre milers de famílies en el procés extraordinari de regularització documental.

La diada de Sant Jordi a Barcelona presenta novetats amb una expansió de la zona peatonal i més espais per a parades de llibres i roses.

La celebració de la diada transformarà el centre de la capital catalana en una gran superilla literària amb importants restriccions de mobilitat i canvis en la recollida de residus.

Un acte vandàlic ha provocat un incendi de vegetació i ha afectat la circulació ferroviària a la Conca de Barberà, activant el pla Ferrocat.

La flor, present en la llegenda de la Mare de Déu de Misericòrdia, es manifesta en el ric patrimoni modernista de la ciutat.

El Departament de Cultura ha donat un mes al propietari de la residència d'estiueig de l'expresident Francesc Macià a Alcarràs per realitzar obres de conservació, mentre la Fiscalia de Lleida investi…

El nou batlle, que ja havia estat regidor, va rebre la vara de comandament de mans de la vídua del seu predecessor.

El sector expressa una gran preocupació per la proliferació del depredador i demana al Govern indemnitzacions àgils i justes pels atacs al bestiar.

La Biblioteca Pública de Lleida va acollir la commemoració amb la presència de representants del Govern i una dramatització literària.

La iniciativa, en col·laboració amb l'Ajuntament de Cambrils, busca fomentar la recerca i la divulgació científica en aquest àmbit.

El consistori ha adjudicat 15 llicències mitjançant un concurs públic, mentre que tres ubicacions han quedat desertes i es tornaran a oferir el 2027.

Virusroomescape, l'empresa creadora de jocs d'escapisme reconeguts internacionalment com Tao o Velatoria, han obert una nova sucursal a la localitat de Pineda de Mar, amb la finalitat d'oferir 4 noves experiències de màxima qualitat.

La ciutat de Tortosa es prepara per a una jornada castellera històrica que commemorarà els aniversaris dels Castellers de Tortosa.

La nova direcció del partit a la Ràpita busca augmentar la militància i consolidar-se com una alternativa de govern per a les pròximes eleccions municipals.

Els Mossos d'Esquadra busquen el conductor d'un vehicle que va atropellar un ciclista a la TP-2002 i va fugir del lloc dels fets.

La Comissió Territorial d'Urbanisme de la Generalitat ha aprovat la modificació del POUM que transformarà l'antic traçat ferroviari en un gran passeig urbà.

La multinacional danesa, encarregada de les noves ambulàncies a Girona, reafirma el seu compromís amb el SEM i explora el mercat nacional.

Una nova publicació revisita el llegat de la que va ser la discoteca més gran d'Europa, un punt de trobada per a diverses generacions.
276 articles de 14212
Carregar més notícies